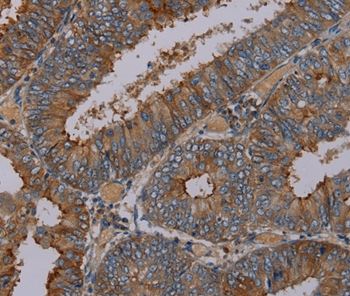

Peptide YY antibody
10-1765
Product group Antibodies
Overview
- SupplierBiosynth
- Product NamePeptide YY antibody
- Delivery Days Customer7
- CertificationResearch Use Only
- UNSPSC12352203
Related products
Product group Antibodies
Anti-Peptide YY/PYY AntibodyA04223-1-CARRIER-FREE
ApplicationsImmunoHistoChemistry
ReactivityHuman
TargetPYY
- SizePrice
Product group Antibodies
Anti-PYY-P2 Antibody130-10458
ApplicationsWestern Blot, ELISA
TargetPYY
- SizePrice
Product group Antibodies

PYY Polyclonal AntibodyBS-2265R
ApplicationsImmunoFluorescence, ELISA, ImmunoCytoChemistry, ImmunoHistoChemistry, ImmunoHistoChemistry Frozen, ImmunoHistoChemistry Paraffin
ReactivityHuman
TargetPYY
- SizePrice
Product group Antibodies
ApplicationsImmunoPrecipitation, Western Blot, ImmunoCytoChemistry, ImmunoHistoChemistry
ReactivityMouse
TargetPYY
- SizePrice
Product group Antibodies
Anti-PYY AntibodyHPA010973
ApplicationsImmunoHistoChemistry
ReactivityHuman
TargetPYY
- SizePrice
Product group Antibodies
Peptide YY antibodyGTX85097
ApplicationsELISA
ReactivityHuman, Mouse
TargetPYY
- SizePrice
Product group Antibodies
PYY AntibodyCSB-PA056057
ApplicationsELISA, ImmunoHistoChemistry
ReactivityHuman, Mouse, Rat
TargetPYY
- SizePrice
Product group Antibodies

ApplicationsWestern Blot, ELISA
ReactivityHuman
TargetPYY
- SizePrice
Product group Antibodies
Anti-PYY AntibodyA47245
ApplicationsImmunoHistoChemistry
ReactivityHuman
- SizePrice